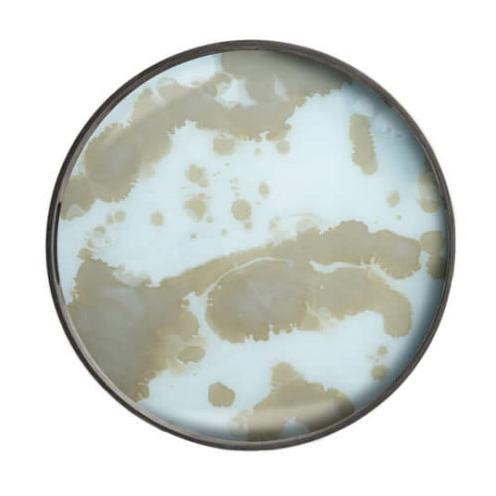
Tray - Round Mist Gold Bronze Mirror

Tray - Round Mist Gold Bronze Mirror
Tray - Round Mist Gold Bronze Mirror
Couldn't load pickup availability
Distinctive and luxurious, the Mist Gold tray instantly lights up a space with its sunny colours, modern patterns and invigorating bursts of gold.
The contrast between its dark wooden rims and bright glass bases further highlights the exquisite tints of gold that are prevalent throughout the collection.
This Tray is a practical go-to option for everyday use, or even a lovely gift.
• Colour: Mottled Bronze and Brown
• Dimensions - 410mm Diameter x 40mm High
- Please allow 5-10 days delivery. Delivery costs are dependent on the size of the item and the delivery address. If you need a more specific time frame, please contact us info@shibui.co.nz
Shipping & Delivery
Shipping & Delivery
The prices specified on all our items exclude the cost of delivery.
Please note there has been a slight increase to our courier charges due to increases from our delivery networks.
• Please use a street address as delivery is not possible to a PO Box.
• A business address may be preferable if you are not going to be home.
• Please let us know if you have any specific delivery requirements.
Shipping Costs
Auckland: Small Items - $12, Large Items - $20
Auckland Rural: Small Items - $18, Large Items - $27
Rest of North Island: Small Items - $21, Large Items - $25
South Island: Small Items - $18, Large Items - $35
South Island Rural: Small Items - $21, Large Items - $39
Rural Deliveries
For a non-urban address please choose the Rural shipping option (this includes beach towns, and outskirts of towns etc). If you are uncertain if your delivery is rural, please contact us to check.
Furniture & Larger Items
An initial $50 fee will be charged, followed by a separate invoice to be sent once shipping prices (calculated on size and weight) have been confirmed.
Please note: Selecting the incorrect delivery zone can result in delays to your delivery. Please ensure that you select the correct item size and regional zone.
If you have any queries please phone 096232727 or email info@shibui.co.nz and we will get back to you as soon as possible.